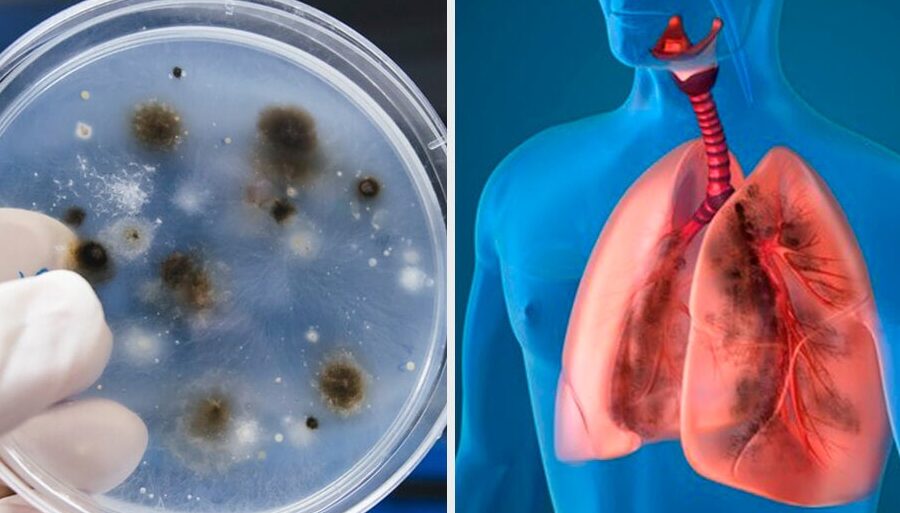

Aspergilosis: enfermedad causada por el hongo Aspergillus fumigatus

La aspergilosis es una enfermedad infecciosa oportunista causada por el hongo Aspergillus fumigatus. Este hongo se encuentra en diversos ambientes como el suelo, plantas y material en descomposición. Sin embargo, no todas las personas desarrollan la enfermedad, ya que se necesita tener un sistema inmunitario comprometido, como ocurre en casos de enfermedades crónicas, VIH o lupus.
La principal vía de infección de la aspergilosis es la inhalación de los esporos del hongo. Una vez inhalados, los esporos pueden colonizar los pulmones y causar una infección. Los síntomas más comunes de la aspergilosis incluyen fiebre por encima de 38°C, tos con sangre o flema, sensación de falta de aire, congestión nasal y dificultad para oler.
Existen diferentes tipos de aspergilosis, siendo los más comunes la aspergilosis pulmonar y la aspergilosis invasiva. La aspergilosis pulmonar afecta a personas sin antecedentes de enfermedades pulmonares y los síntomas incluyen pérdida de peso, tos persistente, tos con sangre, fatiga excesiva y falta de aire. Por otro lado, la aspergilosis invasiva es el tipo más grave y ocurre cuando el hongo se multiplica en los pulmones y se propaga por la sangre. Los síntomas pueden incluir fiebre, dolor en el pecho, tos persistente, dolor en las articulaciones, dolor de cabeza y hinchazón en la cara.
La aspergilosis se transmite principalmente mediante la inhalación de los esporos presentes en el ambiente. También puede ocurrir la transmisión a través de la inyección de los esporos en la córnea. El riesgo de infección es mayor en personas con sistema inmunitario debilitado, como aquellas con VIH, lupus, trasplantes de órganos o que utilizan medicamentos inmunosupresores.
El diagnóstico de la aspergilosis se realiza mediante la evaluación de los síntomas, el historial médico y diferentes pruebas como el examen de esputo, el análisis de sangre para detección de anticuerpos o la cultura del tejido infectado. En cuanto al tratamiento, generalmente se incluye el uso de antifúngicos como el Itraconazol o la Anfotericina B para eliminar el exceso de hongos y controlar la infección. En casos más graves, puede ser necesario el uso de corticoides para aliviar rápidamente los síntomas y mejorar la acción de los antifúngicos. En situaciones de aspergilosis pulmonar o invasiva con la formación de una masa de hongos (aspergiloma), puede ser recomendada una cirugía para extirpar los tejidos afectados.
Prevención de la aspergilosis en personas inmunodeprimidas
La prevención de la aspergilosis en personas inmunodeprimidas es fundamental para evitar la adquisición de la enfermedad. Algunas medidas preventivas que se pueden seguir incluyen:
- Mantener una buena higiene personal, lavándose las manos con regularidad y evitando el contacto con personas enfermas.
- Evitar ambientes con alta concentración de esporas de Aspergillus, como la manipulación de tierra o plantas en descomposición.
- Usar mascarillas protectoras en lugares donde se puedan encontrar altas concentraciones de esporas, como en construcciones o en lugares con exposición a polvo.
- Seguir de cerca las indicaciones del médico en cuanto al uso de medicamentos inmunosupresores o antifúngicos, siguiendo las dosis y duración adecuadas.
Tratamientos alternativos para la aspergilosis
Además de los tratamientos convencionales con antifúngicos y corticoides, existen algunos tratamientos alternativos que se han investigado para el tratamiento de la aspergilosis. Sin embargo, es importante mencionar que estos tratamientos no han sido ampliamente estudiados ni aprobados por las autoridades sanitarias.
Entre los tratamientos alternativos que se han propuesto se encuentran:
- Terapias de reemplazo inmunológico: Algunas investigaciones sugieren que la administración de gammaglobulina intravenosa puede ayudar a mejorar la respuesta inmunológica en personas con aspergilosis.
- Uso de extractos de plantas: Algunos estudios han investigado el uso de extractos de plantas con propiedades antifúngicas, como el ajo o el aceite de árbol de té, como posibles tratamientos complementarios para la aspergilosis.
- Terapias adyuvantes: En algunos casos, se ha considerado el uso de terapias adyuvantes, como la oxigenoterapia hiperbárica o la estimulación magnética transcraneal, para mejorar la respuesta del sistema inmunitario en personas con aspergilosis invasiva.
Es importante destacar que la eficacia de estos tratamientos alternativos no está completamente demostrada y su uso debe ser discutido con el médico tratante.
Investigaciones en curso para el desarrollo de nuevas terapias contra la aspergilosis
La investigación científica continúa en busca de nuevas terapias más efectivas para el tratamiento de la aspergilosis. Algunas líneas de investigación que se están explorando incluyen:
- Desarrollo de nuevos antifúngicos: Se investiga la creación de nuevos antifúngicos que sean más efectivos contra el Aspergillus fumigatus y que tengan menos efectos secundarios en comparación con los tratamientos actuales.
- Inmunoterapias específicas: Se están desarrollando inmunoterapias específicas que ayuden a fortalecer la respuesta inmunológica contra el Aspergillus, mejorando así la capacidad del cuerpo para combatir la infección.
- Terapias genéticas: Se están realizando investigaciones para desarrollar terapias genéticas que puedan modificar el sistema inmunitario de manera específica para mejorar la respuesta frente a la aspergilosis.
Estas investigaciones están en curso y aún se encuentran en sus etapas iniciales, pero representan una esperanza para el desarrollo de terapias más efectivas y seguras para el tratamiento de la aspergilosis.
Preguntas frecuentes
¿Puede la aspergilosis ser contagiosa de persona a persona?
No, la aspergilosis no se transmite de persona a persona. La principal forma de contagio es la inhalación de los esporos del hongo Aspergillus fumigatus presentes en el ambiente.
¿Es posible prevenir la aspergilosis?
Si bien no se puede evitar por completo la exposición al hongo Aspergillus fumigatus, se pueden tomar medidas para reducir el riesgo de infección. Algunas de estas medidas incluyen mantener una buena higiene personal, evitar ambientes con alta concentración de esporas y seguir las indicaciones médicas en cuanto al uso de medicamentos inmunosupresores.
¿Es curable la aspergilosis?
El tratamiento adecuado de la aspergilosis puede ayudar a controlar la infección y aliviar los síntomas. Sin embargo, en casos más graves o en personas con un sistema inmunitario debilitado, la enfermedad puede ser más difícil de tratar y puede requerir un tratamiento a largo plazo.
¿La aspergilosis afecta únicamente a los pulmones?
Aunque la aspergilosis suele afectar principalmente a los pulmones, en casos más graves la infección puede propagarse a otros órganos como el cerebro, los riñones o el corazón.
¿Cómo puedo saber si estoy en riesgo de desarrollar aspergilosis?
Si tienes un sistema inmunitario comprometido debido a una enfermedad crónica, VIH, lupus, trasplantes de órganos o utilizas medicamentos inmunosupresores, corres un mayor riesgo de desarrollar aspergilosis. En caso de tener alguno de estos factores de riesgo, es importante consultar a un médico para una evaluación adecuada.
Conclusión:
La aspergilosis es una enfermedad infecciosa oportunista causada por el hongo Aspergillus fumigatus. Afecta especialmente a personas con un sistema inmunitario debilitado y se transmite principalmente por inhalación de los esporos del hongo. Los síntomas pueden variar y afectar principalmente a los pulmones, pero pueden propagarse a otros órganos. Si bien existen tratamientos disponibles, se están investigando nuevas terapias para mejorar la eficacia y seguridad en el manejo de esta enfermedad.
